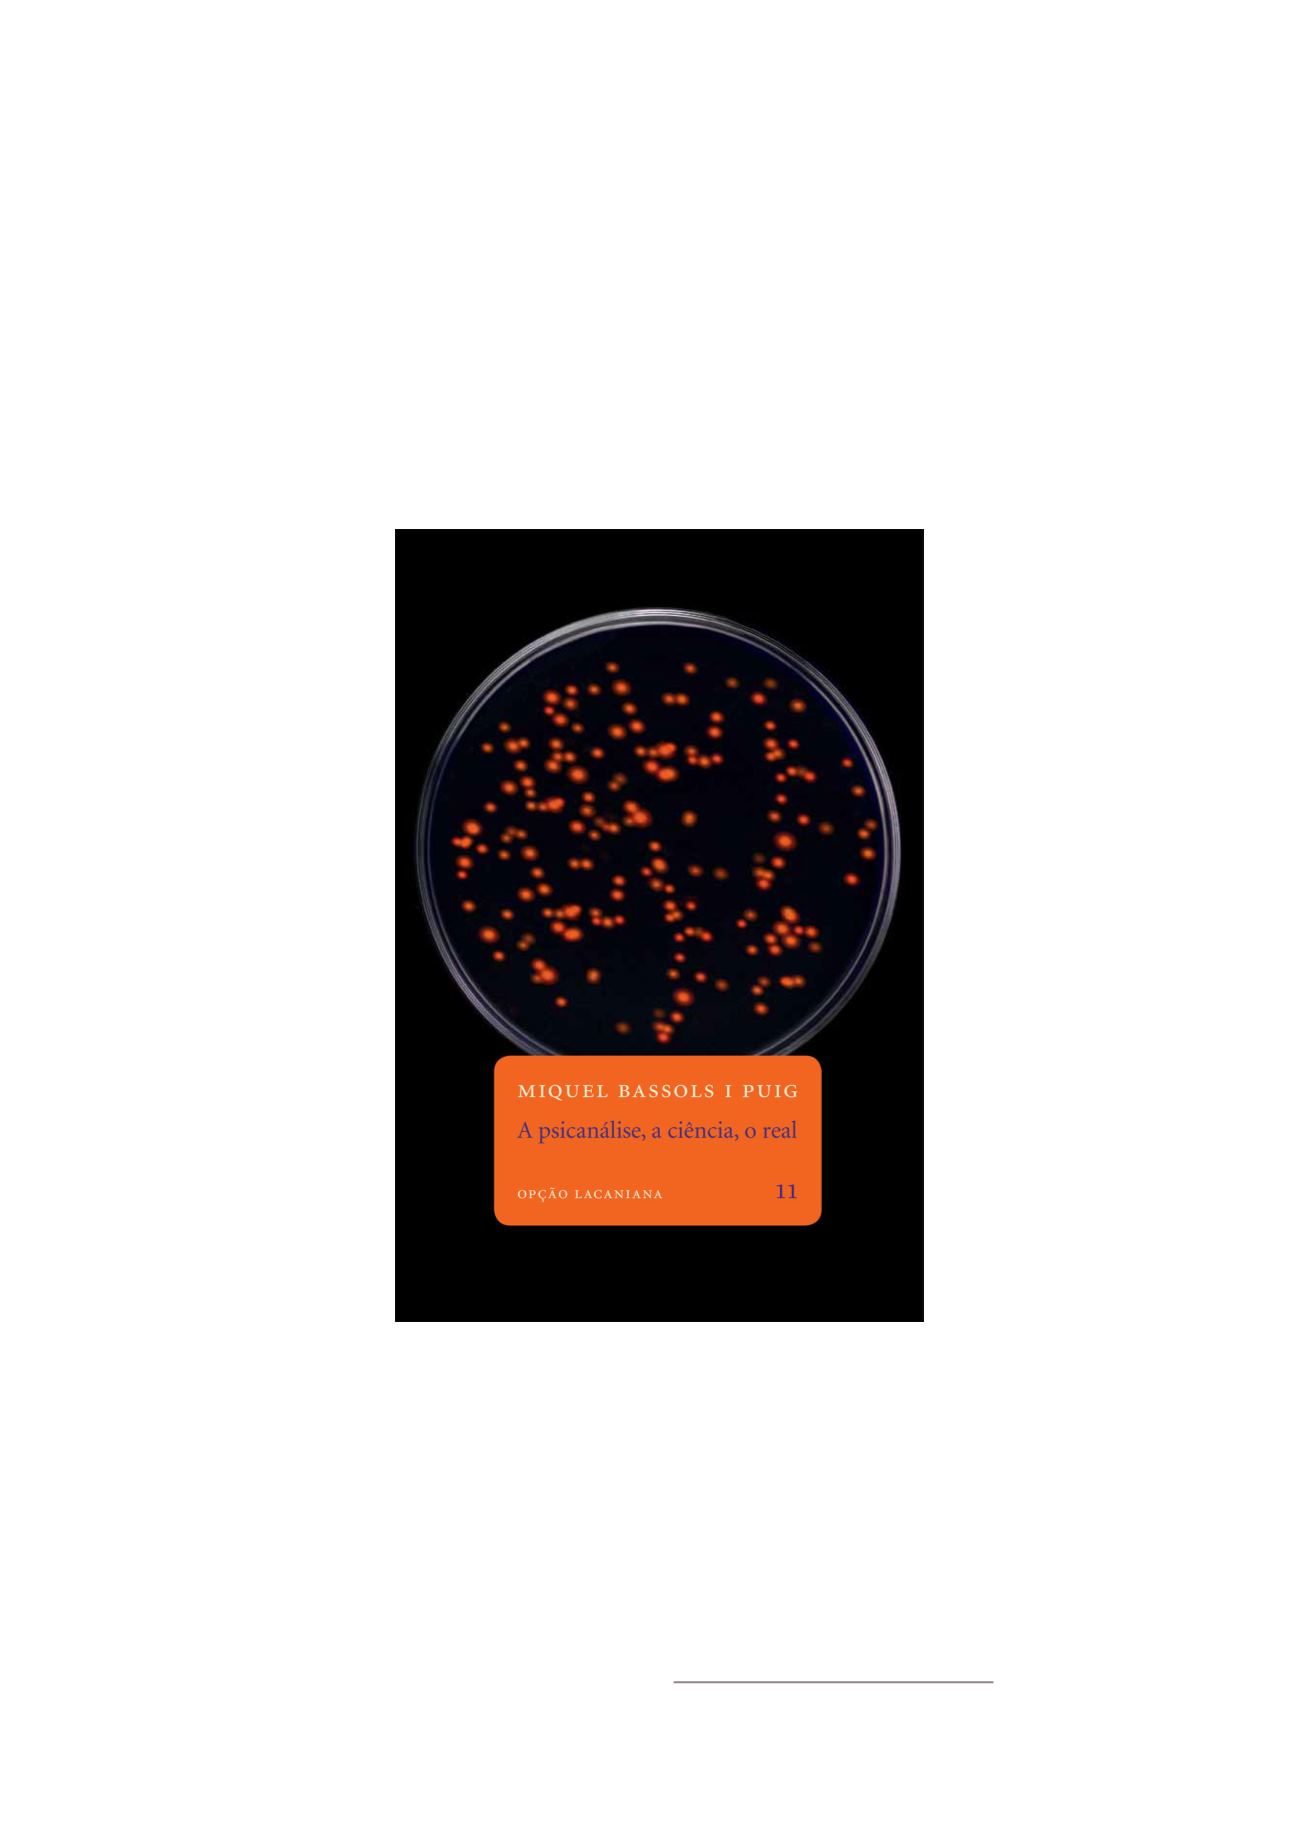
Page Background

2
A psicanálise, a
ciência, o real
Divididos em cinco partes, os vinte e
cinco textos que compõem este primeiro livro
emportuguês deMiquel
Bassols i Puig partem
do real da psicanálise
e a ele retornam de
diferentes
maneiras.
Escritos numa prosa
segura, serena e, quando
preciso, irônica, eles
buscam
delimitar,
entre
os
mundos
simbólicos da ciência e
da arte, a singularidade
da
descoberta
do
inconsciente
por
Sigmund Freud, à
luz das ressonâncias
causadas pelo ensino de
Jacques Lacan. Como
se apreende ao lê-los, a
despeito das recorrentes
e infrutíferas tentativas
hoje empregadas no afã
de localizar o Eu e a consciência em genes ou
neurônios, talvez no intuito de salvaguardá-los
dos efeitos do inconsciente, o real da psicanálise
surge quando se perturbam os campos da
linguagem e da sexualidade.
Com efeito, em vez de corresponder a uma
forma de experimento científico ou mesmo
a uma arte clínica insuflada pelas palavras, a
psicanálise é, a um tempo, uma prática e um
discurso que lida com sujeitos em sua fala e no
gozo de seu corpo. Sujeitos, portanto, tomados
um a um, em face das implicações decorrentes
de serem precedidos pelo desejo do Outro.
Pois bem, na lida com que se transferem tais
implicações, deposita-se passo a passo – e este
é o porto para o qual conflui a argumentação
do autor – o que não cessa de não se escrever,
ausência em torno da
qual, não muitas vezes,
é claro, consegue-
se aceder ao silêncio
próprio e consequente
à vida como ela é.
No mesmo hiato de
bordas
divergentes,
porém conjugadas pelo
verbo, como as orelhas
de um livro, que por
inteiro não se deixam
ficar nem dentro, nem
fora dele, encontra-
se
aqui
(pausa,
para não refletir) o
convite a que você,
leitor, acompanhe o
itinerário psicanalítico
traçado nas páginas
que se seguem.
Miquel Bassols
[AME/ AMP-ELP]
BASSOLS I PUIG, Miquel.
A psicanálise, a ciência, o real
. Rio de Janeiro:
Contra Capa, 2015. (Opção Lacaniana)


















